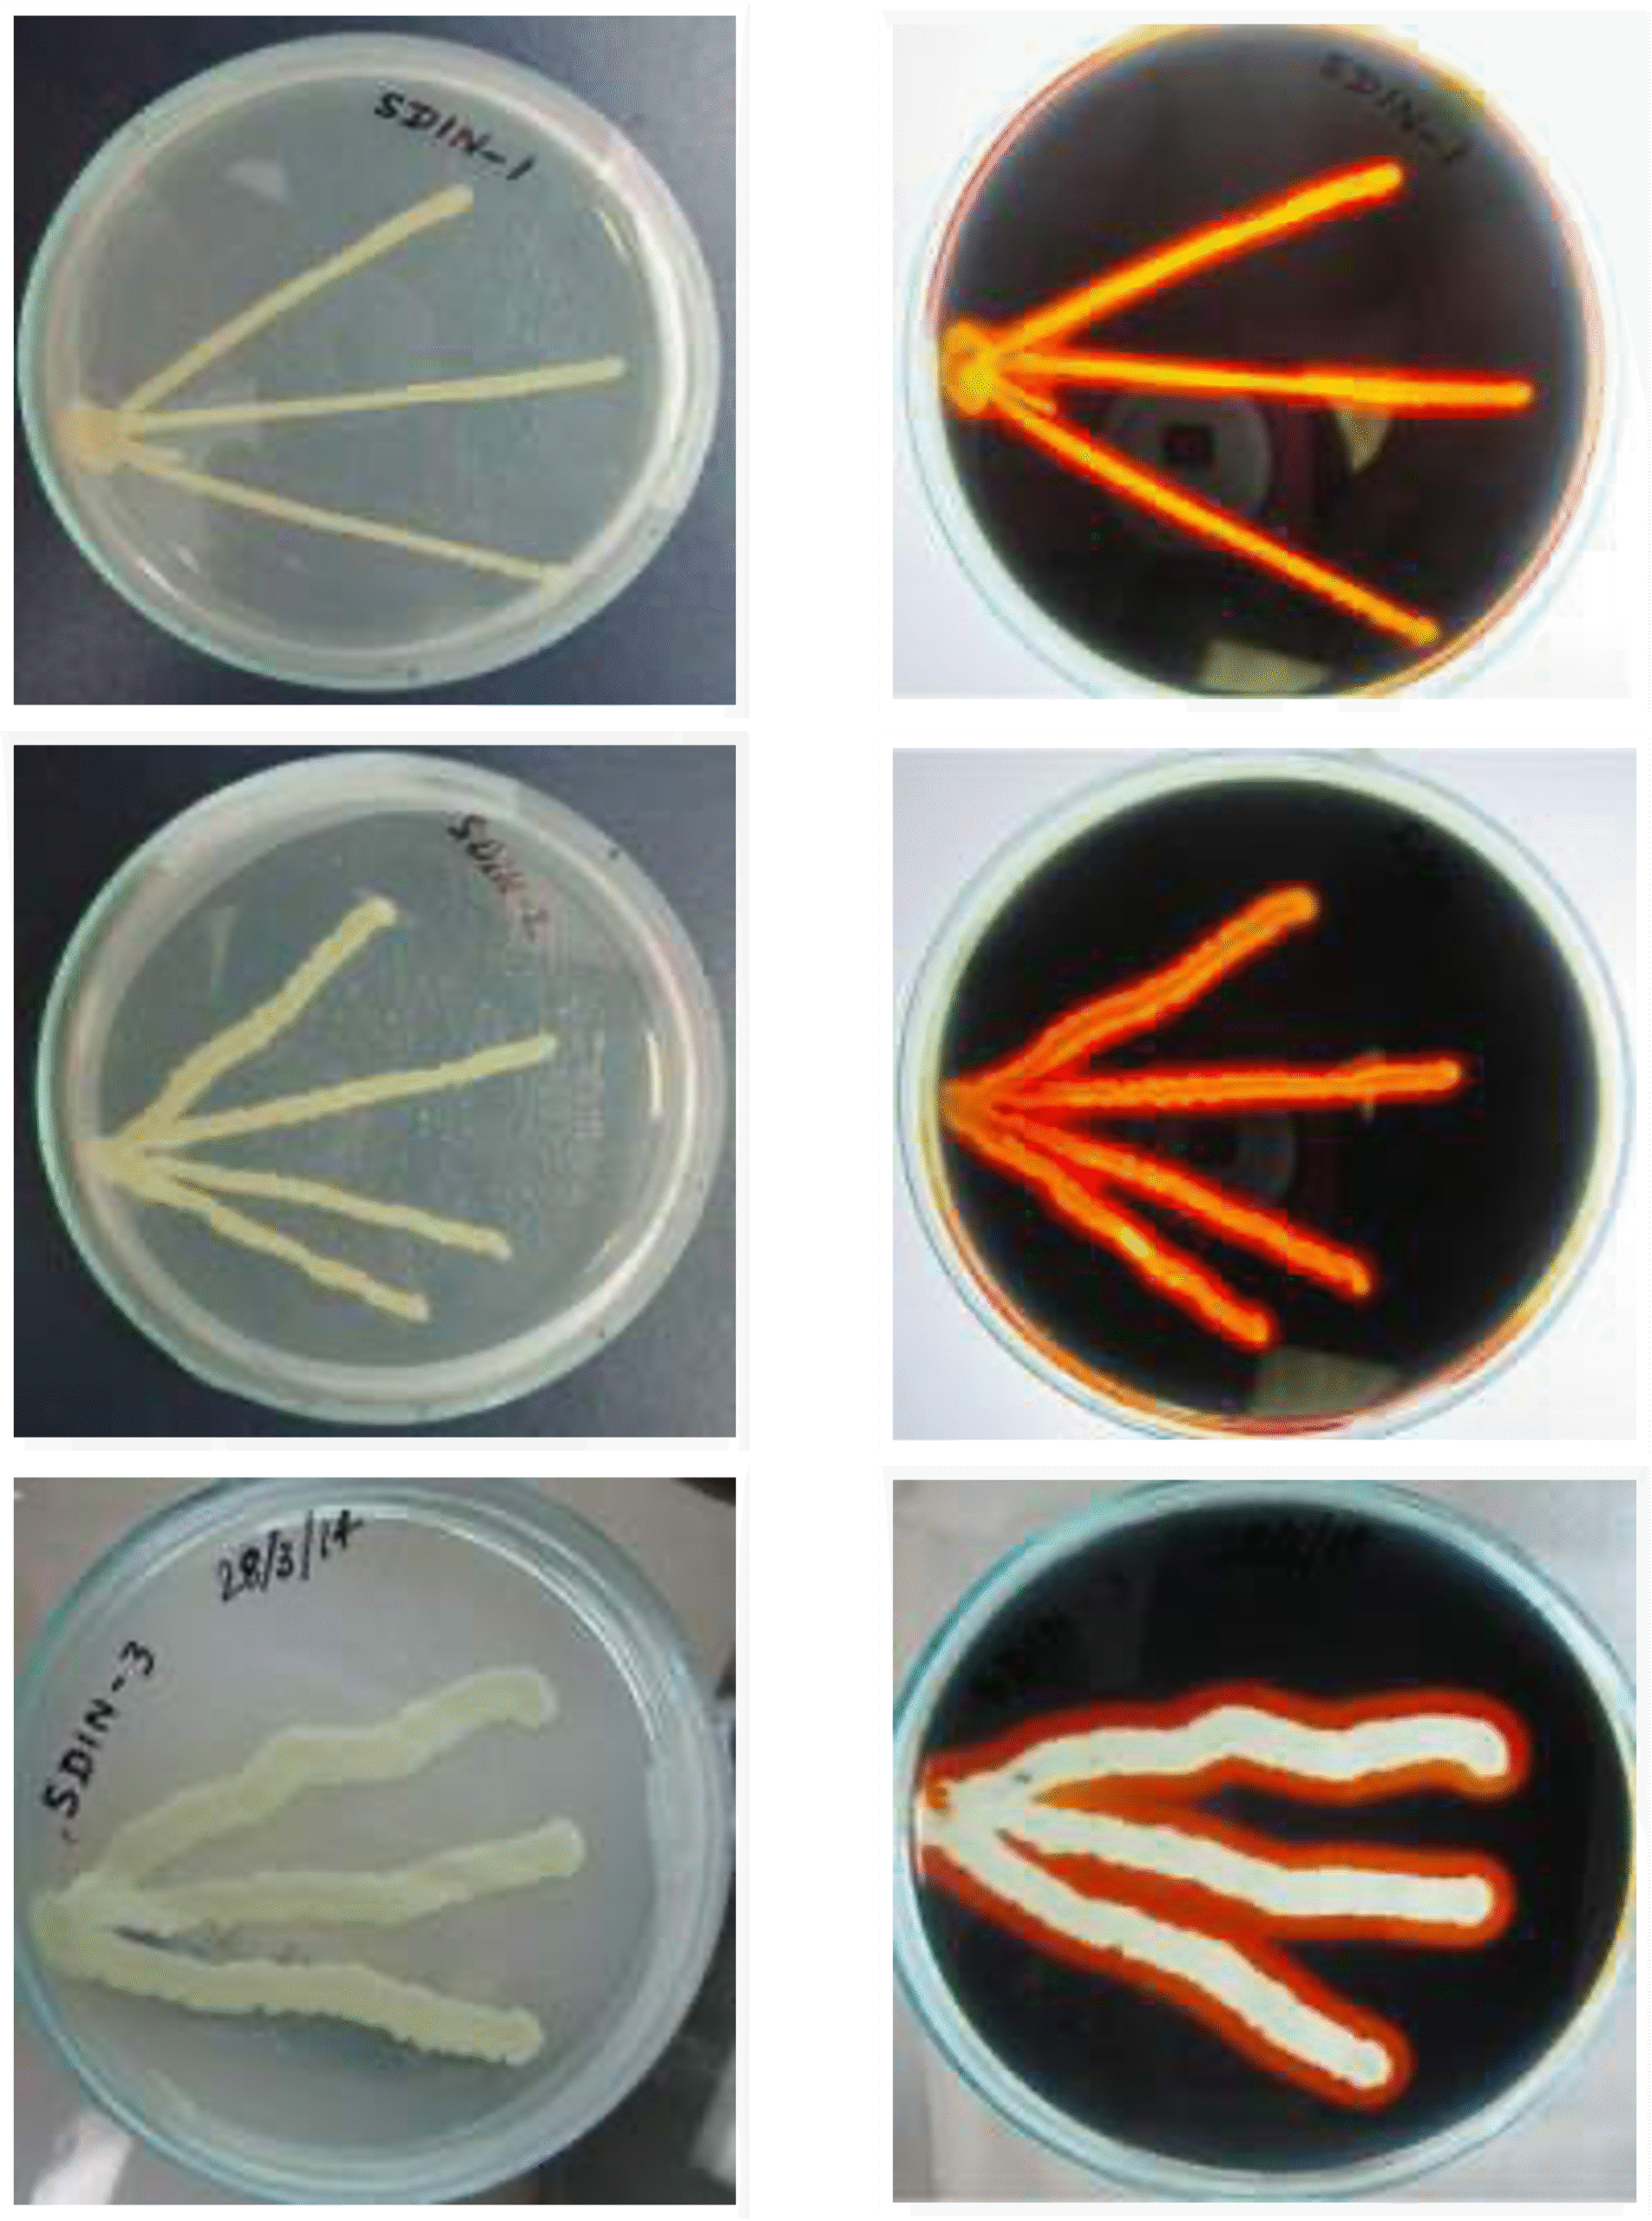
Awesome Image

Name : Petrolize® HTA
Description : Ultra High temperature Stable Enzyme System of Bacterial Alpha Amylase to efficiently break down Starch-Xanthan based Filter-Cakes in 240 Deg F and higher…

Enzymatic Mud Breakers for Starch-Xanthan Muds
Depending on the nature of clean Drill-in fluid used, Starch, Xanthan, and Sized Calcium Carbonate / Salt based drill-in fluid would deposit an impermeable filter cake on the borehole wall. This barrier must be completely broken in order to maximize production rates. Harsh chemicals like Acids and oxidizers often fail to do so leaving residue to plug the screens and drastically reduce production.
Epygen PETROLIZE HTA is a High Temperature stable Alpha Amylase, which, depending on the well temperature will break down starch into simple sugars within 1 to 10 hours time, breaking down the integrity of the filter-cake evenly, allowing the bridging agent to disperse efficiently and cleanly.
This property of efficient but specific hydrolysis results in a breaker that can be pumped evenly down the length of the wellbore, without localized reactivity, as it systematically liquefies the filter-cake and finally promotes even and unrestricted drainage of the reservoir.